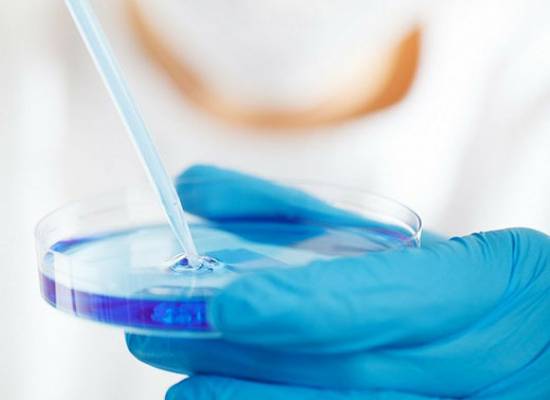

Monitoring/Auditing of Bioequivalence studies
We do independent monitoring of Bioequivalence Studies through various phases of the study like:
Site Initiation
Visit
Visit
We conduct site initiation visits to check the CRO preparedness to carry out the study as per the approved protocol.
In-process Clinical Monitoring Visit
We monitor clinical phases of the study covering the critical aspects like Subject Selection and Enrolment, Check-in, Dispensing of IPs, Dosing and Sample Collection and Safety aspects.
Bioanalytical Monitoring
We do audit of bioanalytical laboratory systems to assess the correctness of assay results through systems and procedures audit, in-house laid down procedures with respect to the regulatory guidelines for method validation, study analysis and data reporting.
We also audit the Instruments and IT procedures, computer systems validation, calibration procedures, Reporting Procedures and laboratory Information management system (LIMS) or any other laid down procedure We audit all Documentation procedures, BioAnalytical report, MD/MV Report, data recording, chromatographic review etc.
CRO
Selection
Selection
We select the CROs for our sponsors by doing a due-diligence audit. We check compliance of GCP/GLP norms as stated in the SOPs and Policy documents
CROs national and international approvals and accreditations
The team’s ability to manage adverse events
Quality and capacity of bioanalytical equipments
QA systems and Quality management system
Auditing/ Monitoring of Clinical Trial Sites
We audit the Clinical Trial sites for phase-II to IV trials of new drugs or patient BE studies. We check the site suitability and infrastructure to conduct the trial and monitor the critical activities of the trial.
Medical Writing for Non-Clinical, Clinical Overview, Safety Reports etc.
We are providing Medical Writing services to complete the dossier. We have team with expertise in writing the CTD modules and process the deficiency letters from the authority to complete the market authorization process.
We Offer :
- Module 2.4 Nonclinical Overview
- Module 2.5 Clinical Overview
- Module 2.6 Nonclinical Summary
- Module 2.7 Clinical Summary
Also we can review the contents of Module 4.0 and 5.0 to be compiled in the CTD.

GCP/GLP Trainings and Workshops
Through our team of expert Auditors and guest speakers from the industry we conduct GCP/GLP training courses and refresher courses to the CRO and pharma industry.
We have conducted online trainings for many international pharmaceutical companies and CROs.
Services offered by best experts of Clinical Research and Medical Writing
